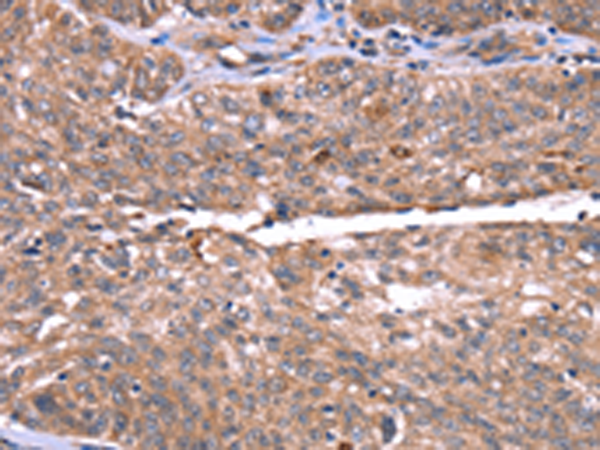

别名:HPRG; HRGP; THPH11应用:IHC
反应种属:Human
规格:50μl/100μl
| Description |
|---|
| This histidine-rich glycoprotein contains two cystatin-like domains and is located in plasma and platelets. The physiological function has not been determined but it is known that the protein binds heme, dyes and divalent metal ions. It can inhibit rosette formation and interacts with heparin, thrombospondin and plasminogen. Two of the protein’s effects, the inhibition of fibrinolysis and the reduction of inhibition of coagulation, indicate a potential prothrombotic effect. Mutations in this gene lead to thrombophilia due to abnormal histidine-rich glycoprotein levels. |
| Specification | |
|---|---|
| Aliases | HPRG; HRGP; THPH11 |
| Swissprot | P04196 |
| Host/Isotype | Rabbit IgG |
| Storage | Store at 4°C short term. Aliquot and store at -20°C long term. Avoid freeze/thaw cycles. |
| Species Reactivity | Human |
| Immunogen | Synthetic peptide of human HRG |
| Formulation | pH7.4 PBS, 0.05% NaN3, 40% Glycerol |
| Application | |
|---|---|
| IHC | 1/50-1/200 |
| ELISA | 1/2000-1/5000 |
![]() |
The image is immunohistochemistry of paraffin-embedded Human breast cancer tissue using P04938(HRG Antibody) at dilution 1/50. (Original magnification: ×200) |
![]() |
The image is immunohistochemistry of paraffin-embedded Human ovarian cancer tissue using P04938(HRG Antibody) at dilution 1/50. (Original magnification: ×200) |
本公司的所有产品仅用于科学研究或者工业应用等非医疗目的,不可用于人类或动物的临床诊断或治疗,非药用,非食用。
暂无评论
本公司的所有产品仅用于科学研究或者工业应用等非医疗目的,不可用于人类或动物的临床诊断或治疗,非药用,非食用。
中文

发表回复